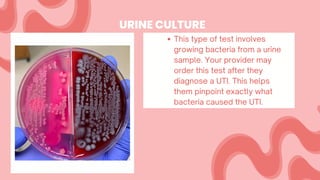
This type of test involves
growing bacteria from a urine
sample. Your provider may
order this test after they
diagnose a UTI. This helps
them pinpoint exactly what
bacteria caused the UTI.
URINE CULTURE

El sistema urinario es el principal sistema excretor del cuerpo, encargado de filtrar la sangre, eliminar desechos y regular la composición química de la sangre. Funciona a través de un proceso de tres etapas: filtración, reabsorción y excreción, implicando principalmente a los riñones y a otros componentes como los uréteres, la vejiga y la uretra. Este sistema puede verse afectado por diversas enfermedades, incluyendo infecciones del tracto urinario, cálculos renales y cáncer de vejiga, que requieren diagnósticos y tratamientos específicos.